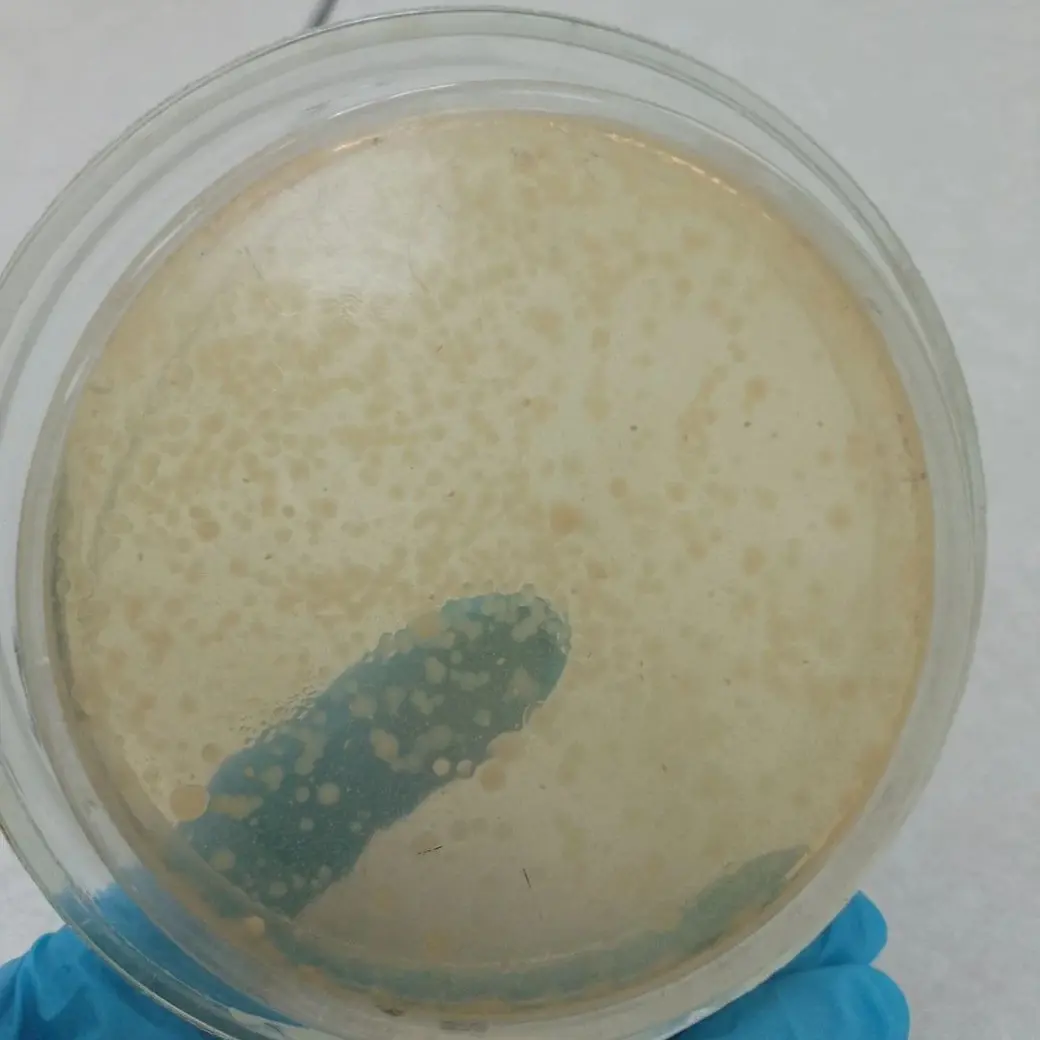
Результаты исследований фонтанов специалистами МЗЦГЭ.

Так, в фонтане, расположенном возле торгового центра «Атриум», фактический показатель бактерий (кишечная палочка) – 620 КОЕ; в фонтане у «Китайской стены» (Первомайская, 31) – 230 КОЕ. Это при том, что норма – 100 КОЕ/100 см³. Нормальная вода оказалась только в сквере 40-летия Победы – 50 КОЕ: ну и то потому, что этот фонтан недавно открыли после ремонта.
Как подчеркивают эпидемиологи, в воде могилевских фонтанов не то, что купаться не рекомендуется – даже руки и лицо полоскать опасно. А вот фото воды наших фонтанов из-под микроскопа, на которых видны многочисленные колонии болезнетворных бактерий: